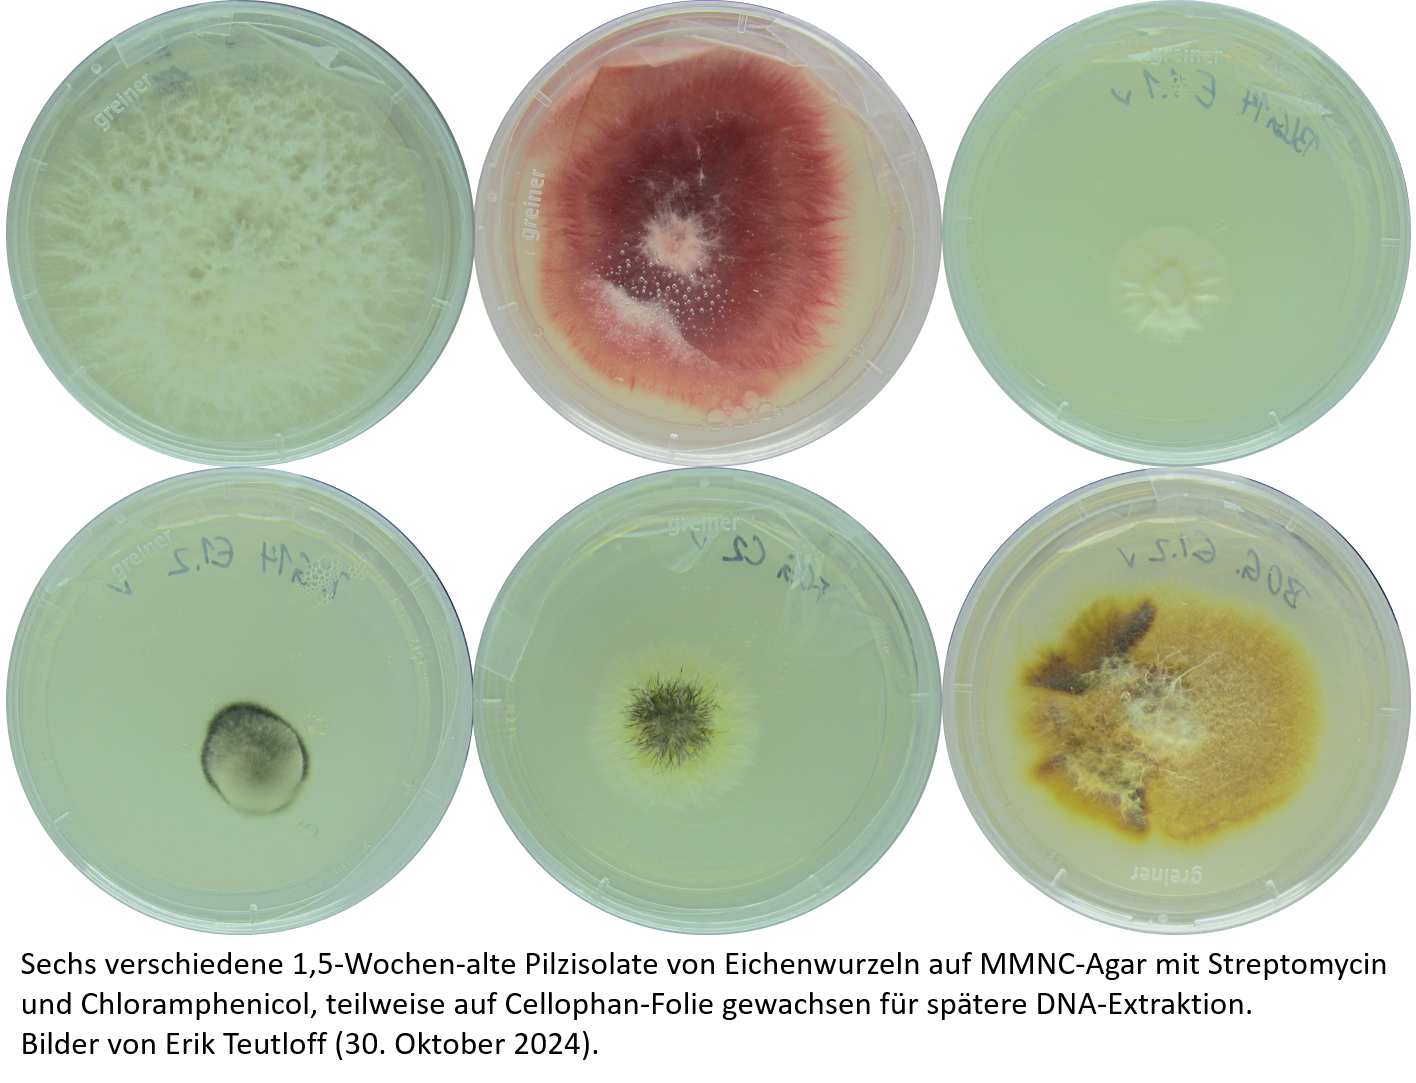
Sechs Pilzisolate aus der Biliothek von pilzlichen Wurzelendophyeten und ECM Pilzen der Kloneichenwurzeln

Erik Teutloff
Kontakt / Adresse
Erik Teutloff
Doktorand
Department Ökologie von Agrarökosystemen
Helmholtz-Zentrum für Umweltforschung - UFZ
Theodor-Lieser-Str. 4 | 06120 Halle/Saale
Email:
Web:

Forschungsinteressen
Ich bin ein Nachwuchswissenschaftler und Doktorand in der Abteilung Bodenökologie unter der Leitung von Prof. Mika Tarkka. Mein besonderes Interesse gilt den Wechselwirkungen zwischen Pflanzen, Bakterien und Pilzen sowie deren abiotischer Umwelt. Vor meinem Eintritt am UFZ befasste sich meine Forschung mit dem Blattmikrobiom von Arabidopsis thaliana und dessen Interaktion mit dem Pilzpathogen Sclerotinia sclerotiorum. Dabei nutzte ich 16S-Metabarcoding, Fluoreszenzmikroskopie und Phytohormonanalysen.
Ein Hauptaugenmerk meiner Arbeit lag auf der Untersuchung der mikrobiellen Gemeinschaftszusammensetzung sowie der ökologischen Funktionen, die die Mikrobiota ihren Pflanzenwirten bieten, insbesondere im Hinblick auf die Widerstandsfähigkeit der Pflanzen gegenüber Blattpathogenen. In Anbetracht der Bedeutung des Bodens als Hauptquelle für pflanzliche Mikrobeninokula verlagerte ich meinen Forschungsschwerpunkt jedoch in den Untergrund – zurück zu den Wurzeln.
Im November 2023 trat ich dem UFZ in Halle bei, um im Rahmen des von der DFG und dem SNF geförderten Forschungsprojekts PhytOakmeter zu arbeiten.
Forschungsprojekte
PhytOakmeter SP5a "Adaptation and acclimation of the clonal oak’s ectomycorrhizal fungi to biotic and abiotic environmental factors"
https://www.uni-marburg.de/en/fb17/phytoakmeter/phytoakmeter-subprojecs/copy_of_project-area-c
Derzeit bin ich Mitglied des Teilprojekts 5 „Ektomykorrhiza“ des PhytOakmeter-Teams. Das übergeordnete Ziel ist es, die Anpassung und Akklimatisierung des Eichen-Holobionten an biotische und abiotische Faktoren zu untersuchen. Die klonale Stieleiche (Quercus robur L. DF159) dient dabei als repräsentative Baumart europäischer Wälder, um die Auswirkungen des Klimawandels auf unsere Wälder besser zu verstehen. Aus der Perspektive des Holobionten betrachtet, untersuchen die einzelnen Teilprojekte die Reaktionen des Pflanzenwirts und seiner assoziierten Mikrobiota auf unterschiedliche klimatische und bodenphysikochemische Bedingungen. Hierfür werden ehemalige landwirtschaftliche Flächen sowie Waldparzellen von Südfrankreich über Deutschland bis nach Finnland genutzt, auf denen die klonalen Eichen seit mehr als 9 Jahren wachsen. Ein besonderer Schwerpunkt liegt dabei auf der Reaktion des Holobionten auf Trockenheit, der Trockenheitsgedächtnisbildung und deren Wechselwirkungen mit der Reaktion auf Fraßschäden, die in kontrollierten Gewächshausexperimenten untersucht werden.
Teilprojekt 5a wird von Prof. Mika Tarkka und Prof. Martina Peter geleitet und befasst sich mit der Rolle ektomykorrhizaler (ECM) Pilzgemeinschaften während der Anpassung und Akklimatisierung der klonalen Eiche. Hierbei kombiniere ich eine mikroskopische Untersuchung von ECM-Morphotypen mit der Analyse extrazellulärer Enzymaktivitäten und ITS2-Sanger-Sequenzierungen derselben Wurzelspitzen, um die von dominanten ECM-Gemeinschaftsmitgliedern bereitgestellten Ökosystemfunktionen zu erforschen. Ein Beispiel für die morphotypische Analyse ist auf dem Bild unten zu sehen.

Ich ergänze diese Analysen durch molekulare Methoden zur Erfassung der mikrobiellen Diversität (ITS2- und 16S-Metabarcoding), um tiefergehende Einblicke in den Einfluss klimatischer und bodenbedingter Faktoren auf die Gemeinschaftszusammensetzung und die damit verbundenen ökologischen Dienstleistungen für den Pflanzenwirt zu gewinnen. Dieses Wissen soll dazu beitragen, die Zukunft unserer Waldbäume im Klimawandel besser vorherzusagen und beispielsweise Aufforstungsmaßnahmen auf ehemaligen landwirtschaftlichen Flächen zu koordinieren sowie bestehende Wälder zu schützen.
Die Rolle ektomykorrhizaler Pilze (ECM) und pilzlicher Wurzelendophyten der klonalen Eiche bei der Förderung des Pflanzenwachstums und der Stressresilienz
Als persönliches Nebenprojekt habe ich Dutzende Pilz-Isolate aus Eichenwurzeln entlang der europäischen Transekt-Parzellen gesammelt. Ich plane, deren wachstumsfördernde Eigenschaften an der klonalen Eiche zu testen. Auf diese Weise hoffe ich, potenzielle Schlüsselspezies zu identifizieren, die künftig zur Steigerung der Baumresilienz gegenüber extremen Wetterereignissen wie Trockenheit beitragen können.
Lebenslauf
seit Oktober 2023
Doktorand
Helmholtz-Zentrum für Umweltforschung - UFZ in Halle (Saale) in der Abteilung Bodenökologie
Projekt: "Anpassung und Akklimatisierung der ektomykorrhizalen Pilze der Kloneiche an biotische und abiotische Umweltfaktoren"
März 2023 bis Oktober 2023
Wissenschaftlicher Mitarbeiter mit akademischem Abschluss
Friedrich-Schiller-Universität Jena, Institut für Mikrobiologie: Plant-Microbiosis Nachwuchsgruppe
Projekt: Untersuchung der frühen Kolonisierung der Phyllosphere von Arabidopsis thaliana von Bodenbakterien
Oktober 2020 bis Februar 2023
M. Sc. Mikrobiologie
Friedrich-Schiller-Universität Jena, Institut für Mikrobiologie: Plant-Microbiosis Nachwuchsgruppe
Masterarbeit: "Balance in pflanzlicher Baterienrekrutierung beeinflusst die Wiederstandsfähigkeit gegen pilzliche Invasion der Phyllosphäre"
Oktober 2017 bis Oktober 2020
B. Sc. Biochemie und Molekularbiologie
Friedrich-Schiller-Universität Jena, Matthias-Schleiden-Institut für Pflanzenphysiologie, Molekulare Botanik
Bachelorarbeit: "Analyse von systemischen Jasmonsäuresignalen mithilfe von Arabidopsis thaliana Reporterlinien"
Konferenzbeiträge
Poster
September 2023:
Erik Teutloff, Jisna Jose, Rayko Halitschke, Aurélie Jost, Patrick Then, Matthew Agler (2023), "Balance in pflanzlicher Baterienrekrutierung beeinflusst die Wiederstandsfähigkeit gegen pilzliche Invasion der Phyllosphäre", VAAM 2023 (Vereinigung für Allgemeine und Angewandte Mikrobiologie), Göttingen (Deutschland)
April 2023:
Erik Teutloff, Jisna Jose, Rayko Halitschke, Aurélie Jost, Patrick Then, Matthew Agler (2023), "Balance in pflanzlicher Baterienrekrutierung beeinflusst die Wiederstandsfähigkeit gegen pilzliche Invasion der Phyllosphäre", Symposium: Bridging Phyllosphere and Rhizosphere Research, Jena (Deutschland)
